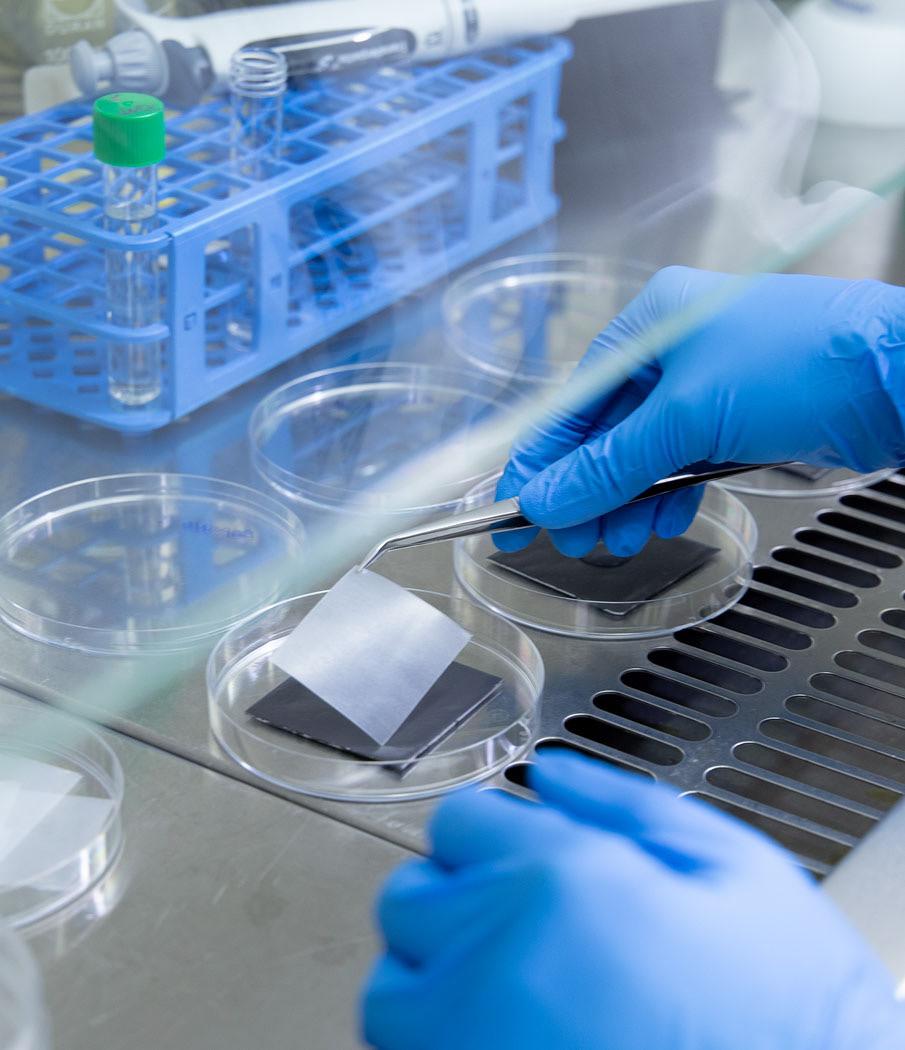

Tecnologías avanzadas en materiales
Aditivos, recubrimientos, resinas, pinturas, tintas y caracterización

Tekniker es especialista en el desarrollo, deposición y caracterización de aditivos, recubrimientos, resinas, pinturas y tintas.
Gracias a su alta especialización, ofrece soluciones innovadoras que mejoran las propiedades de los materiales, proporcionando mayor resistencia, durabilidad y eficiencia.
Estas características clave son fundamentales para optimizar y mejorar productos en diversas aplicaciones industriales, obtener resultados excepcionales y un alto rendimiento.
Diseño de formulaciones a medida Asesoramiento experto
Productos innovadores y de alto rendimiento
Tecnologías

Síntesis y funcionalización de nuevos aditivos
Tecnologías químicas para sintetización de nanomateriales
Funcionalización de aditivos
Encapsulación de sustancias activas
Diseño de estrategias para la liberación controlada de sustancias activas
Valorización de la biomasa
Tecnologías de dispersión de aditivos
Tecnologías mecánicas
Tecnologías químicas
Desarrollo de resinas sostenibles
Síntesis de resinas intrínsecamente reciclables
Síntesis de resinas con funcionalidades avanzadas
Funcionalización de resinas
Recubrimientos
Tecnología sol-gel
Desarrollo de pinturas avanzadas
Desarrollo de soluciones biobasadas
Optimización de procesos de aplicación
Desarrollo e impresión de tintas funcionales
Desarrollo de tintas funcionales y decorativas
Deposición de tintas sobre distintos sustratos
Tratamientos superficiales físicos y químicos de sustratos
Aumento de la durabilidad de las tintas
Caracterización de materiales
Caracterización de emulsiones y dispersiones
Caracterización térmica
Caracterización química
Caracterización morfológica
Caracterización física
Caracterización mecánica
Ensayos de envejecimiento y durabilidad
Características estéticas y de acabado

Caracterización en condiciones de uso
Análisis de resistencia
Garantía de rendimiento y durabilidad
Simulación de escenarios exigentes
Ensayos avanzados
Aseguramiento de la fiabilidad de los materiales
Contacto
Miren Blanco miren.blanco@tekniker.es
